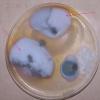

08-06-2026 17:00
François BartholomeeusenGood day everyone, On June 5 2026, I collected de

08-06-2026 10:16
I don`t have a clou about this fungus,it is not in

07-06-2026 15:10
 William Slosse
William Slosse
Hello everyone,On 05-06-26, I found following asco

05-06-2026 11:02
Thomas Læssøehttps://svampe.databasen.org/observations/10596691

07-06-2026 12:09
 François Freléchoux
François Freléchoux
Bonjour, Voici une brève description de ce qui m

07-06-2026 12:43
Steve ClementsBojour. This was a strange find on a stick on my

12-07-2015 00:05
 Nedim Jukic
Nedim Jukic
This one from the same locality as the previous on

06-06-2026 17:44
Steve ClementsBonjour, This disco was on planed wood 3 x 1.5 cm

14-08-2016 23:15
 Alex Akulov
Alex Akulov
Dear friendsCan you help me to find the descriptio
What fungus produces a silvery sheen and black droplets ?
Stephen Martin Mifsud,
17-11-2022 21:18
 I am examining a presumed fungus that produce a silvery sheen under the epidermis and exudates some sort of tiny black droplet on the leaf surface. I have dissected small leaf segments (0.5-1.0 mm) and dropped them on some media perhaps I can cultivate the fungus. This was found on Ferula melitensis which is quite resistant to fungal phytopathens. I dont think it is a soot fungus , but I am all ears to suggestions!
I am examining a presumed fungus that produce a silvery sheen under the epidermis and exudates some sort of tiny black droplet on the leaf surface. I have dissected small leaf segments (0.5-1.0 mm) and dropped them on some media perhaps I can cultivate the fungus. This was found on Ferula melitensis which is quite resistant to fungal phytopathens. I dont think it is a soot fungus , but I am all ears to suggestions!
Björn Sothmann,
17-11-2022 21:39

Re : What fungus produces a silvery sheen and black droplets ?
Hii Stephen,
it's not easy to judge based on these macroscopic pictures, but it would be some powdery mildews where you can see the white anamorph and the dark chasmothecia.
Björn
Stephen Martin Mifsud,
20-11-2022 20:23

Re : What fungus produces a silvery sheen and black droplets ?
Thank you Björn. I have dropped some small pieces on Sabourad and PDa and see what I get and report back. I was confused with the 'black droplets'
Stephen Martin Mifsud,
22-11-2022 20:39

Re : What fungus produces a silvery sheen and black droplets ?
Well we have something workable (arrows) . I guess the mildew in question is the white fluffy colony. I will subculture from this mycelium and in the meantime check if there are some conidiophores/condia to lead to some identification. I am interested coz I seldom see this common endemic plant infected. Underlying is a dull green presence (Penicillium-ish)